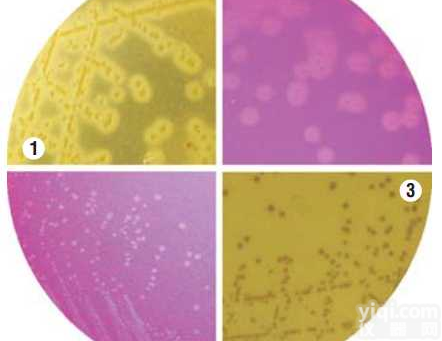
单增<em>李斯特</em>氏菌验证<em>培养基</em>

90mm李斯特菌显色培养基<单核细胞增生李斯特氏菌检验>
- 品牌:南京便诊
- 型号:BKMW1203S
- 产地:南京
- 供应商:南京乐诊生物技术有限公司
- 供应商报价:¥280
- 标签:90mm李斯特菌显色培养基<单核细胞增生李斯特氏菌检验>、90mm李斯特菌显色培养基<单核细胞增生李斯特氏菌检验>价格、90mm李斯特菌显色培养基<单核细胞增生李斯特氏菌检验>厂家、、、南京乐诊生物技术有限公司

【商品名称】
90mm李斯特菌显色培养基<单核细胞增生李斯特氏菌检验>南京便诊公司
【规格编号】
产品编号 | 名称 | 规格 | 供应商 |
BZW12094 | LB1 增菌液 | 225ml | 南京便诊 |
BZW1831B | LB2 增菌液 | 10ml | 南京便诊 |
BZW1203R | PALCAM 琼脂 | 90mm | 南京便诊 |
BKMW1203S | 李斯特菌显色培养基 | 90mm | 南京便诊 |
BZW14136 | 木糖发酵管 | 5ml | 南京便诊 |
BZW14135 | 鼠李糖发酵管 | 5ml | 南京便诊 |
BZW1203J | 含0.6%酵母浸膏的胰酪胨大豆琼脂 | 90mm | 南京便诊 |
| BZW1203K | 含0.6%酵母浸膏的胰酪胨大豆琼脂 | 200ml | 南京便诊 |
| BZW14481 | SIM 动力培养基 | 5ml | 南京便诊 |
| BZW14351 | 缓冲葡萄糖蛋白胨水 | 2ml | 南京便诊 |
| BZW12005 | 血琼脂 | 90mm | 南京便诊 |
| BZW12028 | 血琼脂 | 200ml | 南京便诊 |
| BZW1001J | 无菌脱纤维绵羊血 | 10ml | 南京便诊 |
| BZW14109 | 葡萄糖发酵管 | 5ml | 南京便诊 |
| BZW14130 | 麦芽糖发酵管 | 5ml | 南京便诊 |
| BZW14126 | 甘露醇发酵管 | 5ml | 南京便诊 |
| BZW14133 | 七叶苷发酵管 | 5ml | 南京便诊 |
| BZW1203L | 含0.6%酵母浸膏的胰酪胨大豆肉汤 | 7ml | 南京便诊 |
| BZW1203T | 李氏菌选择性培养基 | 90mm | 南京便诊 |
| BZW1203U | 牛津琼脂 | 90mm | 南京便诊 |
| BZW12097 | 缓冲李氏菌增菌肉汤 | 225ml | 南京便诊 |
| BZW1209A | LPM 琼脂 | 90mm | 南京便诊 |
| BZW1209B | Half–Fraser 培养基 | 225ml | 南京便诊 |
| BZW1209C | EB 增菌液 | 225ml | 南京便诊 |
| BZW1209D | Fraser 培养基 | 225ml | 南京便诊 |
| BZW1209E | UVM 培养基 | 225ml | 南京便诊 |
| BZW1203V | LM-137 琼脂 | 90mm | 南京便诊 |
| BZW1209F | MFB 培养基 | 10ml | 南京便诊 |
| …… | …… | …… | …… |
产品说明】
本品是一种Z基本的非选择性培养基,含有氮源、碳源和微量无机盐适合一般细菌的生长繁殖。因含有动、植物两种蛋白质,苛养菌也可利用其中的营养进行增殖。
【技术标准】
【用途】
用于单增李斯特氏菌分离培养
【贮藏条件】
2~8℃,避光储存,拆封后及时放入冰箱冷藏;
【保质期】
6个月;
【注意事项】
1、检查平板内是否干裂或染菌,如长菌请勿使用;
2、请在洁净的环境下操作,避免杂菌干扰;
3、在冰箱储存很久的培养基容易出现一些冷凝水,请在洁净的环境下将水倒出,然后在培养箱放置10-30Min,待其表面干燥后再接种;或在使用前,提前一到两周放置室温即可;
4、 弃物处理:使用后应高压灭菌或焚烧后按一般垃圾处理,也可按专业技术人员指示方法处理。
【生产公司】
公司名称:南京便诊生物科技有限公司
地 址:南京市江宁区东山街道上元大街808号
联系电话:025-52838289,85099525,13951923346,18951960612
传 真:025-52838289
信 箱:njbianzhen@163.com
Q Q: 85026057 2232629373 945313800 QQ群:71118106(检验帝国)
网 址:www.njbianzhen.cn www.njbianzhen.com
【公司简介】
南京便诊生物科技有限公司是专业生产一次性成品培养基等微生物产品的专业性公司,质量参照《中华人民共和国药典》2010年版、《国家食品药品检验标准》和《临床医学检验手册》的产品质量标准及检验方法执行,达到临床试剂要求。公司技术团队通过不断的改进生产工艺及生产设备,使其产品质量不断提高,得到很多新老客户的大力认可,并有很多老客户自发的帮我们介绍客户,在此,我代表我们公司全体人员向你们表示Z真诚的感谢,同时我们会更加努力,进一步提高,推动微生物行业的发展,为我们各位检验人员提供方便、快捷、准确的产品
公司名称:南京便诊生物科技有限公司
地 址:南京市江宁区东山街道上元大街808号【同类产品】
电 话:025-65016260、65016261、52838289、85099525
传 真:025-52838289
网 址:www.njbianzhen.cn
www.njbianzhen.com
信 箱:njbianzhen@163.comQ Q:85026057
【同类产品】
产品编号 | 名称 | 规格 | 供应商 |
BZW12011 | LB肉汤 | 7ml | 南京便诊 |
BZW12012 | 硫乙醇酸盐流体培养基(FT) | 40ml | 南京便诊 |
BZW12013 | 改良马丁培养基 | 40ml | 南京便诊 |
BZW12014 | 10%氯化钠胰酪胨大豆肉汤(均质袋装 | 225ml | 南京便诊 |
BZW12015 | 营养肉汤[NB][普通肉汤培养基] | 200ml | 南京便诊 |
BZW12016 | 平板计数琼脂培养基(PCA) | 70mm | 南京便诊 |
BZW12017 | 平板计数琼脂培养基(PCA) | 90mm | 南京便诊 |
BZW12018 | 0.1%蛋白胨水溶液[0.1%蛋白胨水清 | 9ml | 南京便诊 |
BZW1201A | 沙氏琼脂培养基 | 7ml | 南京便诊 |
BZW1201B | pH7.0氯化钠-蛋白胨缓冲液 | 200ml | 南京便诊 |
BZW1201C | R2A琼脂培养基 | 90mm | 南京便诊 |
BZW1201D | 平板计数琼脂 | 200ml | 南京便诊 |
BZW1201E | 营养琼脂[NA][牛肉膏蛋白胨琼脂] | 200ml | 南京便诊 |
BZW1201F | MPC琼脂培养基 | 90mm | 南京便诊 |
…… | …… | …… | … |
我们为您提供专业的标准菌株、菌液;
具体的产品说明。。。。
更多的产品介绍。。。。。
请登陆南京便诊公司网站(www.njbianzhen.cnwww.njbianzhen.com );
我们的淘宝网站:双手指淘宝店http://shop67322957.taobao.com/
热线电话:
025 52838289、85099525、65016260、65016261、13951923346,18951960612;
我们将为您提供优质产品、贴心服务,让您省心、省时!